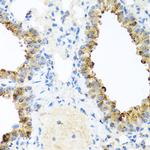
Ninein Antibody in Immunohistochemistry (Paraffin) (IHC (P))

Search
Invitrogen
Ninein Polyclonal Antibody
{{$productOrderCtrl.translations['antibody.pdp.commerceCard.promotion.promotions']}}
{{$productOrderCtrl.translations['antibody.pdp.commerceCard.promotion.viewpromo']}}
{{$productOrderCtrl.translations['antibody.pdp.commerceCard.promotion.promocode']}}: {{promo.promoCode}} {{promo.promoTitle}} {{promo.promoDescription}}. {{$productOrderCtrl.translations['antibody.pdp.commerceCard.promotion.learnmore']}}
图: 1 / 4
Ninein Antibody (PA5-96974) in IHC (P)

Please note: We are reviewing Western blot images included in the antibody testing data in our catalog, including those provided by third parties. Unless expressly labeled or annotated as “raw-unedited”, Western blot images included in the antibody testing data in our catalog may have been edited, optimized or otherwise adjusted for presentation.
产品信息
PA5-96974
种属反应
宿主/亚型
分类
类型
抗原
偶联物
形式
浓度
规格
纯化类型
保存液
内含物
保存条件
运输条件
RRID
产品详细信息
Immunogen sequence: MDEVEQDQHE ARLKELFDSF DTTGTGSLGQ EELTDLCHML SLEEVAPVLQ QTLLQDNLLG RVHFDQFKEA LILILSRTLS NEEHFQEPDC SLEAQPKYVR GGKRYGRRSL PEFQESVEEF PEVTVIEPLD EEARPSHIPA GDCSEHWKTQ RSEEYEAEGQ LRFWNPDDLN ASQSGSSPPQ DWIEEKLQEV CEDLGITRDG HLNRKKLVSI CEQYGLQNVD GEMLEEVFHN LDPDGTMSVE DFFYGLFKNG KSLTPSASTP YRQLKRHLSM QSFDESGRRT TTSSAMT; Positive Samples: Jurkat; Cellular Location: Cytoplasm, centrosome, cytoskeleton, microtubule organizing center
靶标信息
Ninein is a component of subdistal appendages of the mother centriole, localized specifically in the pericentriolar matrix of the centrosome. It may be involved in microtubule minus-end capping, centriole positioning, and protein anchoring. Recent studies have shown that the microtubule nucleation and anchoring at the centrosome are independent processes linked by ninein function. At least five human ninein isoforms with divergent C-terminal domains and two mouse isoforms have been reported. Data indicates that the combined action of domains (C-terminal and N-terminal) might, in the absence of coiled coil region, be sufficient to localize ninein to the mother centriole. Microinjection of antibodies against ninein into metaphase HeLa cells can disrupt the reformation of tubular conformation of proteins within the centrosome following cell division, and consequently lead to dispersal of centrosomal material throughout the cytosol. MTOC (microtubule organizing center) function can be disrupted when anti-ninein antibodies are injected into postmitotic cells. Antibodies against ninein are present in sera from patients with autoimmune diseases that develop autoantibodies to centrosomal proteins.
仅用于科研。不用于诊断过程。未经明确授权不得转售。
篇参考文献 (0)
生物信息学
蛋白别名: Ninein
基因别名: 3110068G20Rik; AI385615; AU024711; Kiaa1565; mKIAA1565; Nin
UniProt ID: (Mouse) Q61043
Entrez Gene ID: (Mouse) 18080, (Rat) 299117




